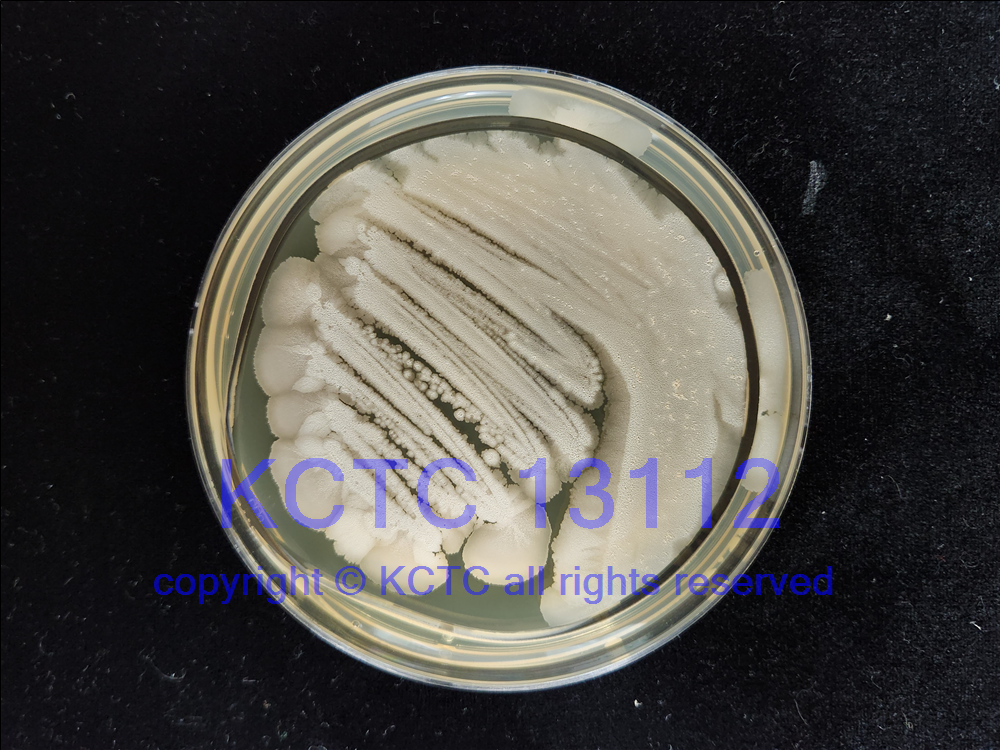

KCTC No.13112
(KCTC Other No.)
Resource TypeBacteria
NameBacillus subtilis
Type StrainNo
Biosafty Level1
LMONo
Synonym
Phylum (ex Phylum)Bacillota (Firmicutes)
Genome Information
History<- Neopharm Co.
SourceFrom kimchi
Other Collection No.18-1
Reference
KCTC Media No.KCTC media No. 98 Tryptic Soy Agar
KCTC media No. 1 Nutrient Agar
Oxygen RequirementAerobic
Temperature37 ℃
pHnetural pH ?? ?? (???? ??)
Incubation Time2 d [???? ???? ????? ??, ?? ? ????? ??? ?? ?? ? ??]